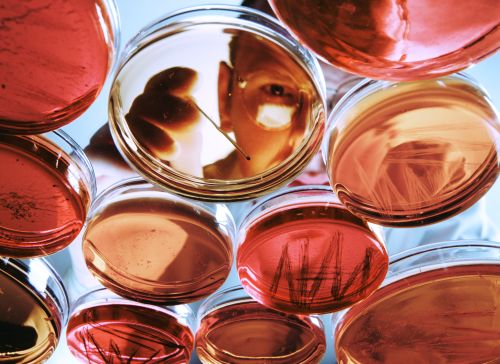

2025 Life Sciences Outlook: Building Preparedness to Mitigate Risks and Capture Human Capital Opportunities
2025 Life Sciences Outlook: Building Preparedness to Mitigate Risks and Capture Human Capital Opportunities
The 2025 Life Sciences Outlook highlights the industry's promising growth, driven by digital advancements, increased investor confidence, and innovative product development.
By embracing these strategies, the life sciences industry can navigate the dynamic landscape and achieve sustainable growth.
2025 Life Sciences Outlook: Navigating Growth and Innovation
The life sciences industry is on the brink of a transformative year in 2025. After navigating a period of significant volatility, the sector is poised for substantial growth, driven by rapid digital advancements, increasing investor confidence, and groundbreaking product development.
Embracing Digital Transformation
Digitalisation is at the forefront of this evolution. The integration of advanced technologies is not only enhancing operational efficiencies but also revolutionising patient care and research methodologies. Companies that leverage digital tools effectively will be better positioned to manage risks and capitalise on new opportunities.
Investor Confidence and Market Dynamics
Investor confidence is on the rise, fuelled by the industry's resilience and potential for innovation. This renewed interest is expected to drive funding towards cutting-edge research and development, paving the way for revolutionary products and therapies. Strategic investments will be crucial in navigating the competitive landscape and achieving long-term success.
Human Capital and Workforce Skills
A key component of this growth trajectory is the strategic analysis of talent and workforce skills. As the industry evolves, so do the demands on its workforce. Companies must focus on building a skilled and adaptable workforce to stay ahead of the curve. This involves not only attracting top talent but also investing in continuous learning and development programs.
Managing Evolving Risks
With growth comes the challenge of managing evolving risks. The life sciences sector must remain vigilant in identifying and mitigating potential threats. This includes staying ahead of regulatory changes, cybersecurity threats, and supply chain disruptions. A proactive approach to risk management will be essential in maintaining stability and fostering innovation.
Conclusion
The 2025 Life Sciences Outlook paints a promising picture for the industry. By embracing digital transformation, fostering investor confidence, strategically analysing human capital, and managing risks, companies can navigate this dynamic landscape and achieve sustainable growth. The future of life sciences is bright, and those who adapt and innovate will lead the way.
Read more here: https://www.aon.com/en/insights/articles/2025-life-sciences-outlook
Contact: Matthew.robinson@aon.co.uk
These are the views of Aon. They do not necessarily reflect the views of Bionow.
While care has been taken in the production of this document, Aon does not warrant, represent or guarantee the accuracy, adequacy, completeness or fitness for any purpose of the document or any part of it and can accept no liability for any loss incurred in any way by any person who may rely on it. Any recipient shall be responsible for the use to which it puts this document. This document has been compiled using information available to us up to its date of publication and is subject to any qualifications made in the document.
This article has been compiled using information available to us up to 2025. Aon UK Limited is authorised and regulated by the Financial Conduct Authority. Registered in England and Wales. Registered number: 00210725. Registered Office: The Aon Centre, The Leadenhall Building, 122 Leadenhall Street, London EC3V 4AN. Tel: 020 7623 5500.